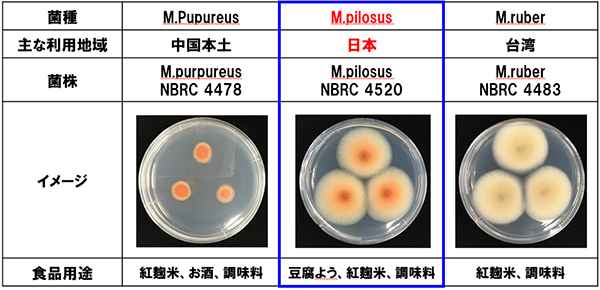
本研究で使用した菌種

世界初※!紅麹(Monascus pilosus)の全ゲノムを解析
腎機能障害をもたらすカビ毒シトリニン※1生成不能を証明
-2020年10月1日 BMC genomics (Springer Nature)誌にて報告-
小林製薬株式会社(本社:大阪市、社長:小林章浩)は、2016年にグンゼ株式会社より、食品素材“紅麹”に関する製造・販売事業を譲り受けました。以来、国内唯一の伝統的発酵法により製造した“紅麹”の機能研究、新製品開発、BtoB事業に取り組んでおります。今回弊社は、奈良先端科学技術大学院大学 先端科学技術研究科 金谷重彦 教授・データ駆動型サイエンス創造センター 小野直亮 准教授との研究において、紅麹菌“Monascus pilosusの全ゲノム”を世界で初めて明らかにし、結果を2020年10月1日 BMC genomics (Springer Nature)誌にて報告いたしました。
※2020年9月 自社調べ 文献検索サイト(pubmed)にて「Monascus pilosus」に関する全ゲノム解析文献を検索した結果(データベース公開より~2020年9月30日)
“紅麹”は米などの穀類にMonascus属糸状菌を繁殖させた鮮紅色の麹で、食用色素や健康食品として広く利用されています。弊社では薬膳料理として長い食経験をもつ“紅麹”の健康効果に着目し、“紅麹菌”の伝統的固体発酵法による大量培養に世界に先駆けて成功するなど、研究を進めてまいりました。この度、次世代シークエンサー※2を使って紅麹菌3種類の全ゲノム解析を行い、日本で主に使われている紅麹菌(Monascus pilosus)には腎毒性の健康被害をもたらすカビ毒シトリニン※1が生成不能であることを明らかにしました。
【研究成果まとめ】
① 主に日本で利用される“紅麹菌”は物質レベルでシトリニン※1を生成しないことを確認
② 主に日本で利用される“紅麹菌”はゲノムにもシトリニン※1の遺伝子がないことを確認
■本研究で使用した菌種
■紅麹培養物のヒートマップ

■シトリニン※1を合成する遺伝子領域

本研究成果より、食品の製造に広く用いられてきた“紅麹(Monascus pilosus)”の全ゲノムが明らかとなりました。本件のようなゲノム解析により、新たな有用成分や安全性に関する研究が一層推進すると期待されます。弊社は今後とも“紅麹”が持つ機能性成分、新たな健康効果の研究を進め、その成果を社会に還元してまいります。
研究成果
■実験手順
- ① 培養:“紅麹菌”を液体培地にて培養
- ② 抽出:“紅麹菌”から遺伝子情報のもととなるゲノムDNAを抽出
- ③ 解析:ゲノムDNA中の情報を次世代シークエンサー※2を用いて解析
日本では主にM.pilosus、台湾ではM.ruber、中国ではM.purpureusが主に食品用途として利用されている。M.ruber に関しては、今回の研究で用いた菌株ではシトリニンを作る遺伝子は存在していませんでしたが、M.purpureusとM.ruberは過去にシトリニンの遺伝子が機能している菌株の報告があります(Shimizu et al., 2005 and Wang et al., 2016)。このことから、現在M.pilosusのみが、ゲノムレベルでカビ毒シトリニン※1を作らない報告のある唯一の“紅麹”となります。今回の発見は、今後のより有益で安全性の高い“紅麹”原料の開発につながる研究成果であると考えられます。
【用語解説】
※1 シトリニン:人体への腎毒性の健康被害が有るカビ毒。欧州食品安全機関(EFSA)では、安全性の観点から紅麹由来のサプリメント中のシトリニンの基準値が2,000μg/kg以下に規制されている。
※2 次世代シークエンサー:大規模な遺伝子配列を解明するため活用される基盤技術。数千から数百万ものDNA分子を同時に配列決定可能。
【2020年 10月1日 BMC genomics (Springer Nature)】
-
○Title:Divergence of secondary metabolites in three phylogenetically close Monascus spiecies (M.pilosus, M.ruber, and M.purpureus) based on secondary metanolite biosynthetic gene clusters.
タイトル:二次代謝生合成遺伝子クラスターに基づく3種の系統発生的に近い紅麹種(M.pilosus、M.ruber、およびM.purpureus)における二次代謝産物の多様性 -
○Yuki Higa, Young-Soo Kim, Md. Altaf-Ul-Amin, Ming Huan, Naoaki Ono, Shigehiko Kanaya
比嘉 悠貴, 金 英寿, Md. Altaf-Ul-Amin, 黄 銘, 小野 直亮, 金谷 重彦
以上


